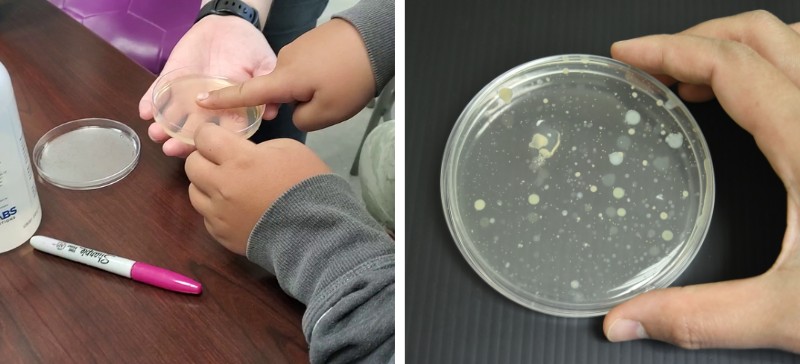

Même si la science est un langage universel, certains élèves du primaire et du secondaire vivant dans les régions très éloignées n’ont pas souvent la chance de la côtoyer au quotidien.
Dans le cadre du programme « Chercheur d’un jour », Jehane Abed, étudiante au doctorat au Centre de recherche en infectiologie du Centre de recherche du CHU de Québec-Université Laval (CRCHU), maintenant stagiaire postdoctorale, s’est rendue dans la petite communauté d’Aupaluk au Nunavik, dans le Nord-du-Québec. Situé à quelques heures de Kuujjuaq, le village nordique d’Aupaluk regroupe près de 230 habitants qui parlent en grande majorité l’inuktitut et l’anglais.

Le village d’Aupaluk. Photo : Jehane Abed.
La mission de Jehane : faire vivre la science aux jeunes élèves d’une école primaire et secondaire à travers divers ateliers le temps d’une journée. L’objectif de cette visite était d’éveiller la curiosité scientifique des enfants et des adolescents ainsi que de les sensibiliser à l’accessibilité des carrières en recherche biomédicale.
« Ces jeunes ont très peu de modèles de scientifiques dans leur communauté. Il est important de leur offrir des perspectives et de les encourager à poursuivre des études en science, leur dire que faire de la recherche, c’est plus accessible qu’ils ne le pensent », souligne-t-elle.
Au menu : sarraus, pipettes et bactéries!
Les élèves de l’école Tarsakallak ont d’abord assisté à une courte présentation sur le corps humain et les bactéries, ces alliés invisibles qui se trouvent un peu partout dans notre organisme.
Ils ont ensuite eu l’occasion de visualiser la présence des microbes sur la peau avec une « gélose nutritive », un mélange de nutriments dont les bactéries se nourrissent et dans lequel elles se développent. En apposant les doigts sur une gélose, par exemple avant et après un lavage des mains, il est possible d’observer le lendemain la prolifération des bactéries.
Cette expérience a permis aux élèves de prendre conscience de l’importance d’une bonne hygiène; ils ont pu constater comment des gestes simples comme le lavage des mains peuvent avoir des répercussions concrètes à un niveau microscopique.
La gélose nutritive et les bactéries. Photo : Nathalie Ruette, professeure de sciences à l’école Tarsakallak.
Ayant revêtu leur sarrau et munis d’une pipette, les jeunes scientifiques en herbe ont ensuite préparé des échantillons dilués avec du colorant alimentaire. Même si la manipulation d’une pipette peut sembler banale, elle requiert pourtant une grande précision et une très bonne dextérité. Un seul faux mouvement et votre échantillon peut être contaminé, voire complètement fichu!
Les apprentis chercheurs ont aussi observé au microscope des bactéries colorées, placées sous une lamelle. Les jeunes, qui pour la plupart en étaient à leur première expérience avec un microscope, étaient captivés par le spectacle qui se révélait à travers l’objectif. Comme dirait un animateur connu, « fascinant »!

Les scientifiques en herbe apprennent le maniement des pipettes et font des observations au microscope. Photo : Nathalie Ruette, professeure de sciences à l’école Tarsakallak.
Et qu’est-ce que ça mange un scientifique en hiver?
Une autre partie importante du travail d’un scientifique est la rédaction de rapports, d’articles et autres publications scientifiques. Bien qu’il soit tentant d’observer des cellules au microscope toute la journée, il ne faut pas oublier que la transmission du savoir et des connaissances est le pain et le beurre du scientifique.
Pour terminer les ateliers, Jehane a présenté aux élèves ses travaux de recherche portant sur la compréhension de la santé globale des Inuit par l’étude de leur microbiome intestinal. En effet, caractériser la composition, la diversité et les fonctions potentielles des bactéries naturellement présentes dans les intestins de jeunes Inuit du Nunavik est une étape préliminaire pour comprendre leurs problèmes de santé et les impacts potentiels de l’industrialisation sur celle-ci.
Bien que la plupart des enfants n’étaient pas tout à fait familiers avec le vocabulaire utilisé, ils étaient tout de même intéressés d’en apprendre davantage sur sa démarche et ses découvertes. Chose certaine, cette journée scientifique en aura inspiré plus d’un!

Jehane présente ses travaux de recherche aux élèves. Photo : Nathalie Ruette, professeure de sciences à l’école Tarsakallak.
Faire vivre la science à nos jeunes
Depuis maintenant 25 ans, le programme « Chercheur d’un jour » offre la chance aux élèves du secondaire et du cégep de vivre une journée immersive dans l’un des laboratoires du Centre de recherche du CHU de Québec-Université Laval.
Lors de leur immersion en laboratoire, les élèves ont l’occasion d’échanger avec des chercheurs, des professionnels de recherche et des étudiants chevronnés, d’expérimenter avec une panoplie d’équipements de haute technologie et de participer à des ateliers pratiques multidisciplinaires.
L’an dernier, « Chercheur d’un jour » s’est également engagé avec l’Association québécoise autochtone en science et en ingénierie (AQASI) afin d’élargir son programme auprès des établissements scolaires des communautés des Premières Nations et des Inuit au Québec.
Pour en savoir plus, rendez-vous sur le site Web de « Chercheur d’un jour ».
En terminant, nous remercions chaleureusement Jehane d’avoir accepté de nous faire part de son expérience, et surtout un grand merci aux jeunes et au personnel de l’école Tarsakallak d’Aupaluk pour leur accueil et leur participation très enrichissante à cette journée de découverte des sciences. Soulignons également la contribution de Sentinelle Nord et des équipes de Gina Muckle et du Dr Richard Bélanger (axe Santé des populations et pratiques optimales en santé) et du Dr Michel G. Bergeron (axe Maladies infectieuses et immunitaires) pour avoir rendu possible l’atelier C1J à Aupaluk.